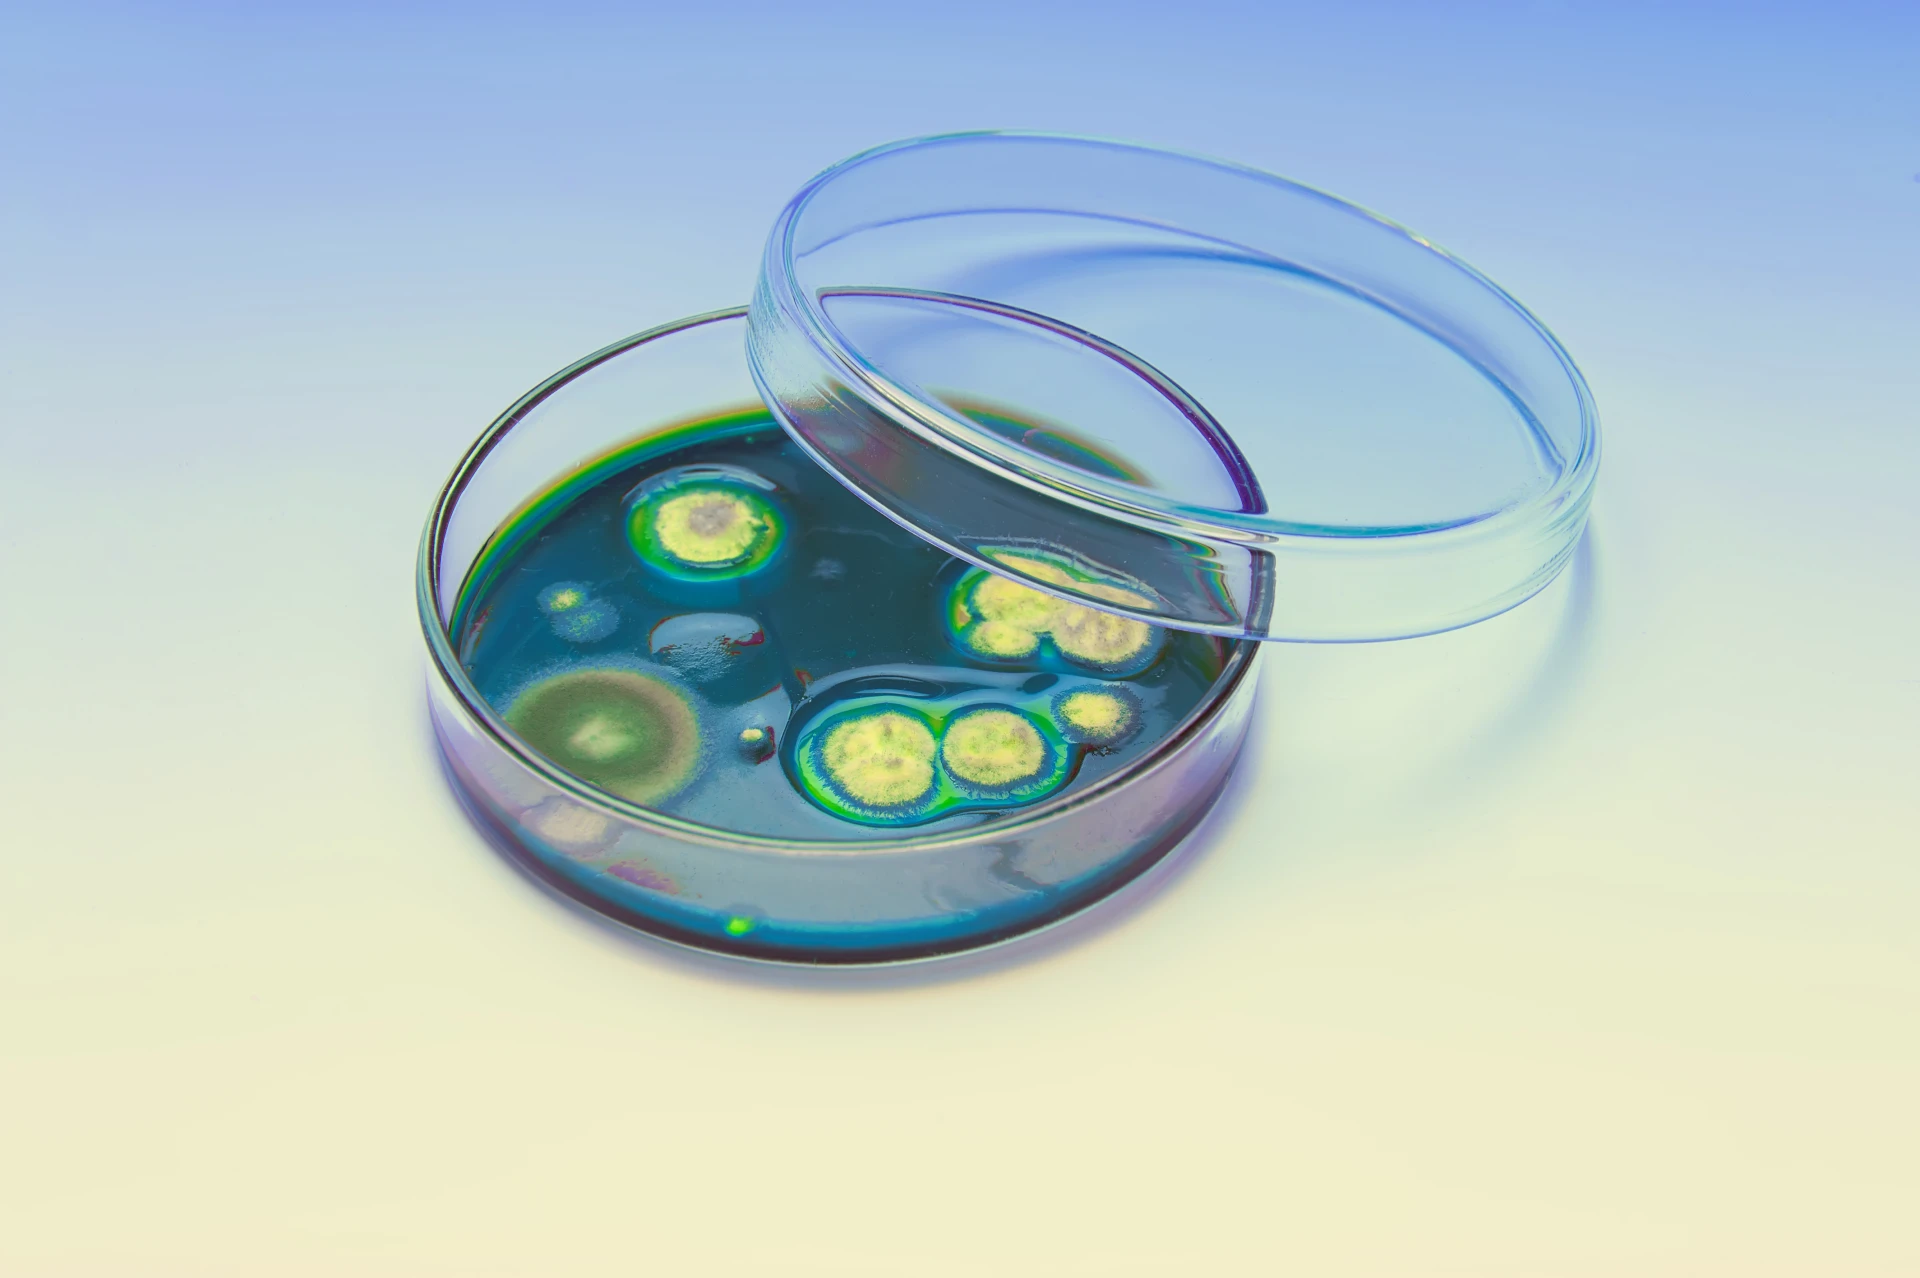
Agentes Biológicos

• MONITOREOS
Monitoreos Ocupacionales
Gestión de Riesgos
Nuestro servicio está orientado a identificar, reconocer y evaluar agentes físicos, químicos y biológicos, así como factores disergonómicos y psicosociales que puedan afectar la salud en el trabajo.
Agentes Físicos
- Ruido por dosimetría/sonometría
- Confort y estrés térmico
- Radiación UV e Iluminación
- Vibración mano-brazo / cuerpo entero

Agentes Químicos
- Partículas respirables e inhalables
- Humos metálicos y gases
- Compuestos orgánicos volátiles

Agentes Biológicos
- Microbiológico en superficie viva
- Microbiológico en superficie inerte

Factores Ergonómicos
- Levantamiento de carga frecuente
- Movimientos repetitivos
- Pantallas de visualización de datos
¿Requieres Asesoría?
Déjanos tus datos y un especialista se pondrá en contacto contigo a la brevedad para evaluar tus necesidades.
Llámanos
Asistencia Inmediata
Escríbenos
informes@esin.com.pe
